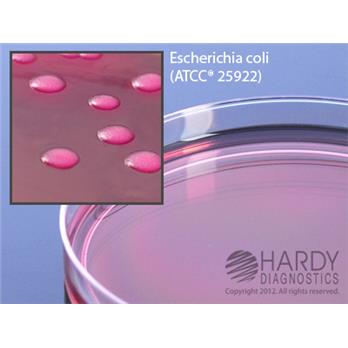

Macconkey Agar, 15x100mm Plate, Box Of 100
|
|
Details:
Features:For the isolation and differentiation of Gram negative bacteria, especially the Enterobacteriaceae groupAdvanced formula controls the swarming of ProteusPolystyrene Petri plates feature raised rings for stacking ability and prevents sliding.Packaged in sleeves of 10 plates in a "breathable " cellulose bag that prevents build-up of condensation and excess moistureThe Hardy Diagnostics manufacturing facility and quality management system comply with cGMP's and have achieved ISO 13485 certification as a medical device manufacturerThomas No. C850X40 This media is identical to Cat. no. G35, however his product has a Petri plate that features a reduced stacking ring (smoother lid) so that it will work smoothly with automated streaking devices.
Additional Information
| SKU | 5328427 |
|---|---|
| UOM | Box of 100 |
| UNSPSC | 41106212 |
| Manufacturer Part Number | G35BX |
